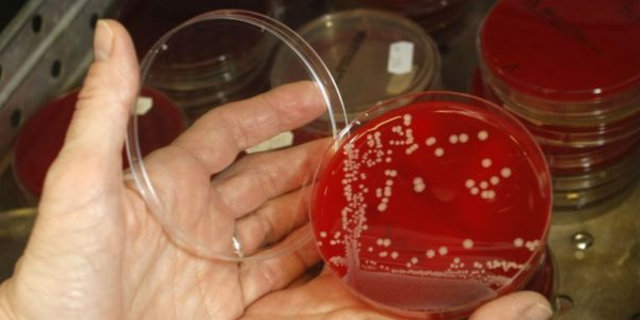

Arkadaşının makyaj fırçasını kullanan kadın felç kaldı
27 yaşındaki genç kadın tekerlekli sandalyeye mahkum oldu!

Bakterinin omurgasını hedef alması sonucu yaşadığı ağrılarla hastaneye kaldırılan Jo, kuvvetli antibiyotik tedavisi de etkili olmayınca felç kaldı.

27 yaşındaki genç kadın, hayatının geri kalanını tekerlekli sandalyede geçirecek.

Yaptığı hatanın farkına varan genç kadın, yaşadığı acılar ve karşı karşıya kaldığı durum sonrası tüm kadınlara seslenerek kendisiyle aynı hatayı yapmamalarını söyledi.

Stafilokok bakterisi genellikle zararsızdır ve pek çok kişinin cildinde veya burnunda bulunur.
Ancak bazı kişilerde ciddi enfeksiyonlara neden olabilir. Bu nedenle kişisel hijyen eşyalarının ortak kullanımından kaçınmak gerekir. Stafilokok, yaralardan bulaşır ve kızarıklık, sivilce, şişkinlik ve hassasiyete neden olabilir.
